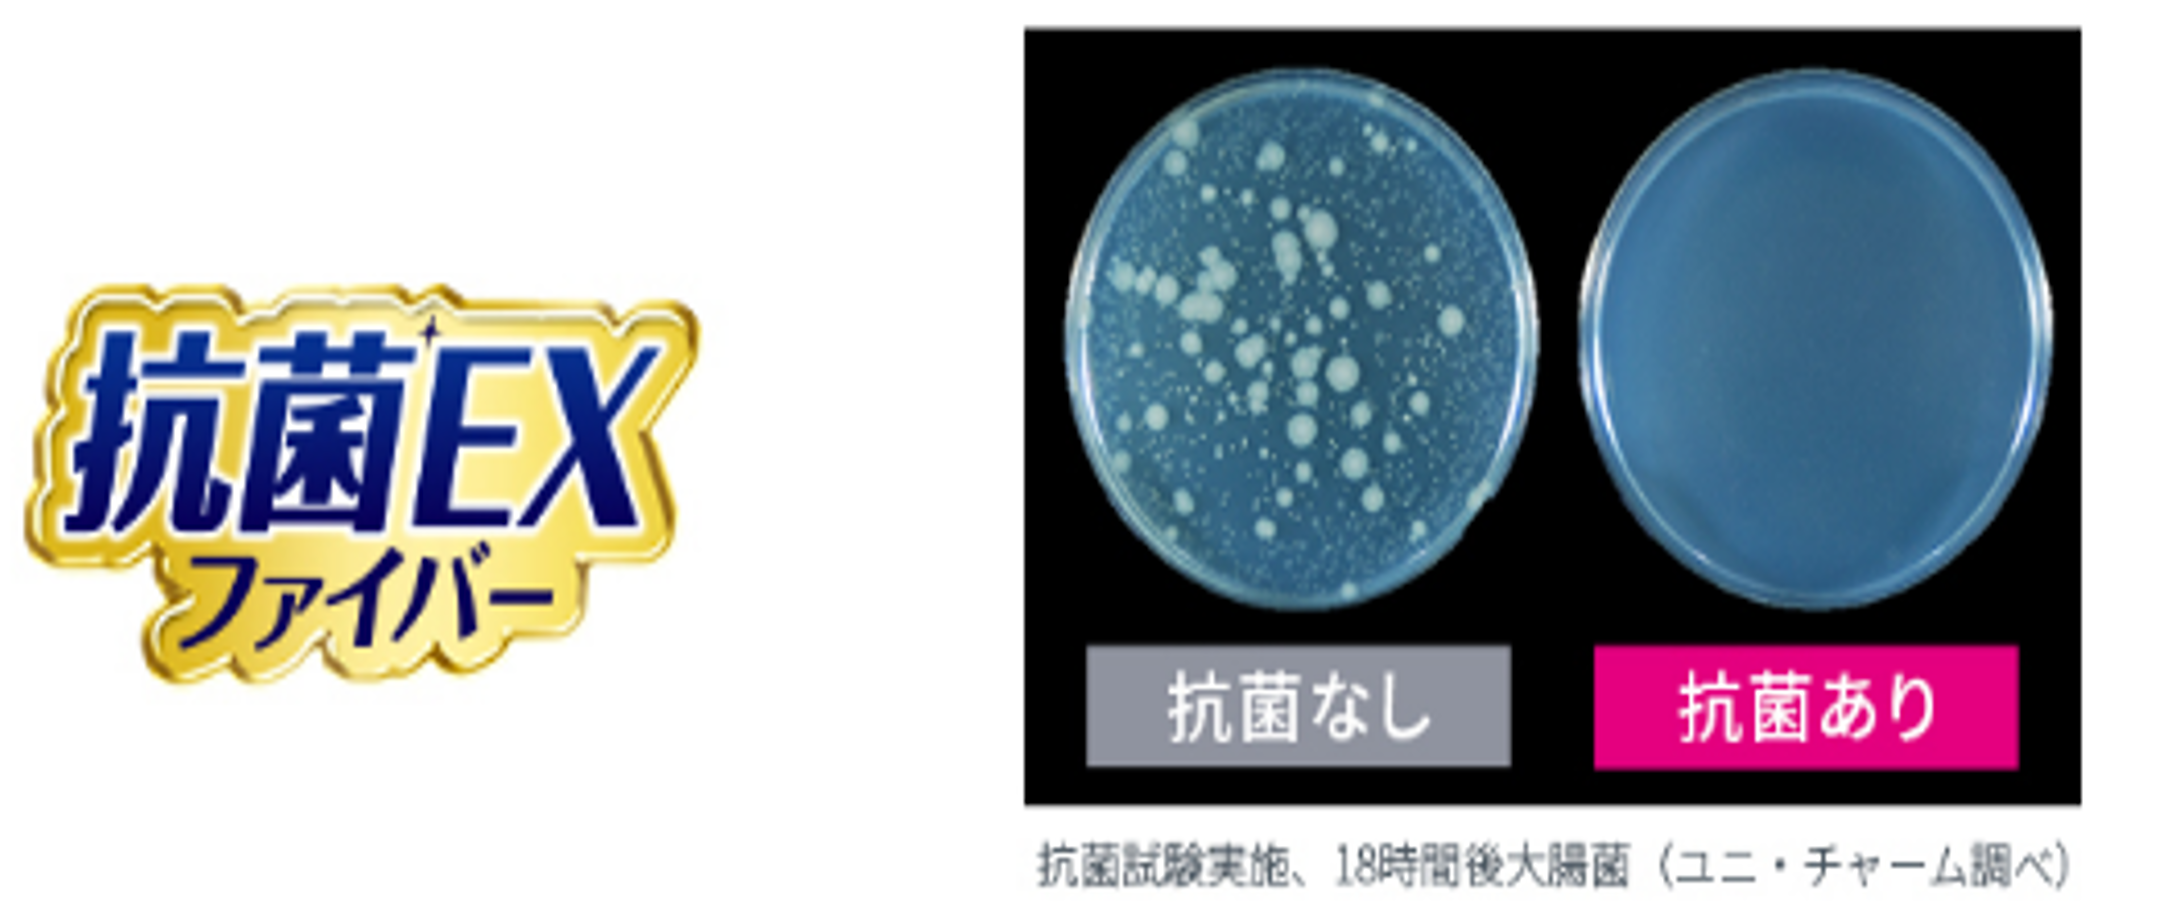

2025年10月07日
ユニ・チャーム、『ウェーブ ハンディワイパー』ホルダーデザインを17年ぶりに刷新
~手にフィットするループ形状で家中のスキマのお掃除をもっと快適に~
ユニ・チャーム株式会社(代表取締役 社長執行役員:高原 豪久)は、お掃除用品ブランド『ウェーブ』から、ホルダーデザインを17年ぶりに刷新した『ウェーブ ハンディワイパー』を、2025年10月7日に全国で発売します。


『ウェーブ ハンディワイパー』
本体+1枚 本体+1枚ケース付きスリム白
発売の背景
ライフスタイルの多様化に伴い、掃除にも「タイパ(タイムパフォーマンス)※1」が求められています。特に毎日の生活の中で発生する細かな汚れを手間なく、短時間で掃除したいというニーズも年々高まっています。当社の調査では、トイレ・洗濯機のまわりのスキマや階段の隅など、掃除機や従来のフロアワイパーでは届きにくい“家中のあらゆるスキマや隅”の掃除に困っている方が6割以上にのぼることが明らかになりました。
そこでこのたび、ホルダーのデザインを刷新し、手にフィットするループ形状で家中のスキマの掃除を可能にする『ウェーブ ハンディワイパー』を発売します。
※1 限られた時間を効率的に使い、できるだけ少ない手間で最大の成果を得ることを重視する考え方




商品の特長
(1)スキマ・隅まで拭きやすいループ形状の新ホルダー
・手にフィットし握りやすいループ形状でスキマ・隅の掃除のストレスを大幅に軽減し、より快適に。
・岡山県立大学デザイン学部との共同開発、デザイン性と機能性を両立。


(2)掃除場所に合わせて握り方を変えられるホルダーデザイン
・タテ持ちや端持ちなど、掃除場所に応じて自由に握り方を変えることが可能。
・テレビ台などの広い面はもちろん、トイレの配線周りや階段の隅、小物の細かなスキマといった手の届きにくい場所にも対応。


(3)「からめる密着構造」でホコリ・髪の毛・砂粒などのゴミをキャッチ※2
・極細な密着ファイバーが、ホコリ・粒ゴミをからめとって離しません。
※2 対象となるホコリやゴミの量によって、取り切れない場合もあります


(4)抗菌※3EXファイバーで、からめ取ったホコリに含まれる菌の増殖を抑制
・抗菌成分を配合したファイバーにより、からめ取ったホコリに含まれる菌の増殖を抑制。
※3 抗菌加工を施した部位の表面でのみ菌の増殖を抑制します。また、すべての菌の抑制をするものではありません

入数・価格
| 商品名 | 入数 | 価格 |
|---|---|---|
ウェーブ ハンディワイパー本体+1枚 |
1枚 |
オープンプライス |
ウェーブ ハンディワイパー本体+1枚 ケース付きスリム白 |
1枚 |
発売時期
2025年10月7日に全国で発売します。
『ウェーブ』ブランドサイト
『ウェーブハンディワイパー』リニューアルを通じて貢献する「SDGs 17の目標」
この商品を発売することは、2015 年に国連で採択された「持続可能な開発目標」(SDGs:Sustainable Development Goals)で定めた 17 の目標のうち、下記に貢献するとユニ・チャームでは考えています。
3. すべての人に健康と福祉を 12.つくる責任 つかう責任
これからも、商品やサービスの提供といった事業活動を通じて、環境問題や社会課題を解決し、SDGsの達成に貢献することを目指します。
<<本件に関するお問い合わせ先>>
一般報道機関の方は、ユニ・チャーム(株) グローバル マーケティング コミュニケーション本部 Love Your Possibilities広報部
TEL:03-6722-1019 Email:brand-pr@unicharm.com
消費者の方は、 ユニ・チャーム(株) お客様相談センター TEL:0120-423-001
